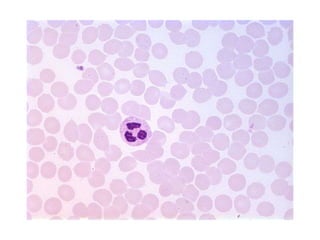

Embed presentation
Downloaded 34 times































This document provides a review of various tissue types, listing each tissue's name followed by its type. It covers simple squamous epithelial tissue, skeletal muscle tissue, pseudostratified ciliated columnar epithelial tissue, dense regular connective tissue, bone connective tissue, simple columnar epithelial tissue, cardiac muscle tissue, nervous tissue, smooth muscle tissue, hyaline cartilage connective tissue, blood connective tissue, fibrocartilage connective tissue, stratified squamous epithelial tissue, adipose connective tissue, and simple cuboidal epithelial tissue. Apologies are made for some pictures being unavailable or not matching the in-class slides.